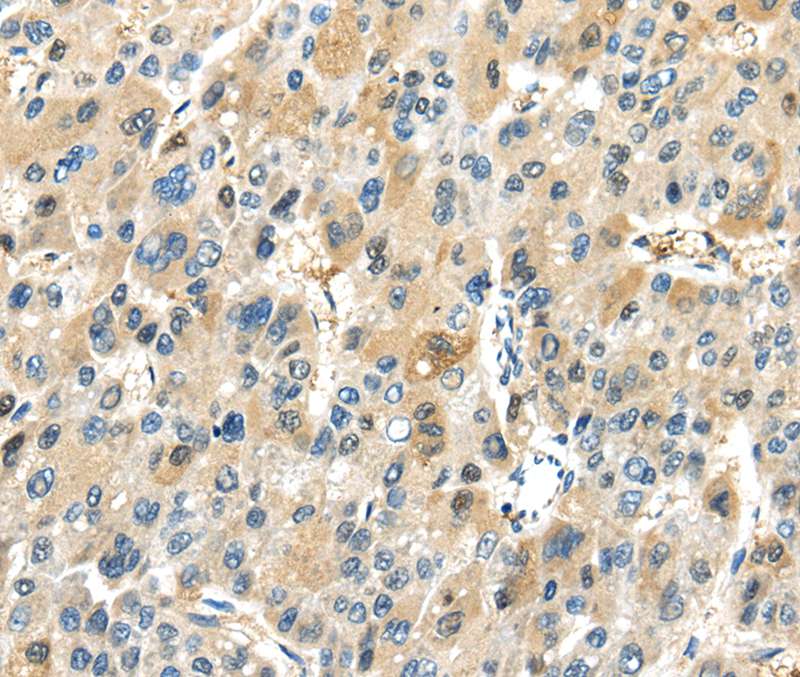

TRAIP Polyclonal Antibody
RD79535A
ApplicationsELISA, ImmunoHistoChemistry
Product group Antibodies
TargetTRAIP
Overview
- SupplierReddot Biotech
- Product NameTRAIP Polyclonal Antibody
- Delivery Days Customer5
- ApplicationsELISA, ImmunoHistoChemistry
- CertificationResearch Use Only
- ClonalityPolyclonal
- Concentration0.8 mg/ml
- ConjugateUnconjugated
- Gene ID10293
- Target nameTRAIP
- Target descriptionTRAF interacting protein
- Target synonymsRNF206, SCKL9, TRIP, E3 ubiquitin-protein ligase TRAIP, RING-type E3 ubiquitin transferase TRAIP, ring finger protein 206
- HostRabbit
- IsotypeIgG
- Scientific DescriptionThis gene encodes a protein that contains an N-terminal RING finger motif and a putative coiled-coil domain. A similar murine protein interacts with TNFR-associated factor 1 (TRAF1), TNFR-associated factor 2 (TRAF2), and cylindromatosis. The interaction with TRAF2 inhibits TRAF2-mediated nuclear factor kappa-B, subunit 1 activation that is required for cell activation and protection against apoptosis.
- Storage Instruction-20°C
- UNSPSC12352203